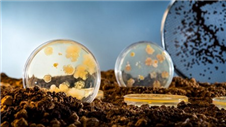

תחומי פעילות
- שיקום קרקעות מזוהמות
- טיפול ביולוגי בפסולת מסוכנת, קרקעות, בוצה ממתקני טיהור שפכים ובתי זיקוק שפכים תעשייתיים המכילים מזהמים אורגניים
אודות עסק
ביוסויל הינה חלוצת תחום הטיפול הביולוגי בפסולות אורגניות מסוכנות במדינת ישראל, ונחשבת למוקד ידע ובעלת מומחיות רבה בתחום. מזה למעלה מעשור מפעילה ביוסויל בנאות חובב, מתקן לטיפול ביולוגי בקרקעות מזוהמות, בוצות ממתקני טיפול בשפכים, בוצות ממתקני זיקוק ושפכים תעשייתיים המכילים מזהמים אורגניים.
הטכנולוגיה המתקדמת שבה עושה ביוסויל שימוש נשענת על עשרות שנים של מחקר אקדמי ויישומי, ואשר נמשכים למעשה לכל אורך שנות פעילותה, באמצעות מחלקת המחקר והפיתוח והמעבדה הביולוגית שמפעילה ביוסויל.
ההשקעה הרבה של ביוסויל במחקר תחום הטיפול הביולוגי הקנתה לה יכולת ייחודית בכל הקשור לטיפול בפסולת מסוכנת "קשת פירוק", המכילה מזהמים בריכוזים גבוהים וכן בעלי מאפיינים כימיים ופיזיים אשר מקשים על יצירת תנאים אופטימליים הנדרשים לתהליך הטיפול.
במהלך שנות פעילותה טיפלה ביוסויל במאות אלפי מ"ק של פסולות מסוכנות בעלות מורכבות טיפול משתנה וממגוון רחב של מקורות זיהום ותהליכי ייצור, כל זאת לשביעות רצונם המלאה של לקוחותיה.
ביוסויל מרכזת לתוכה את הידע הייחודי, המוניטין והניסיון הרב המצוי אצל כל אחד משותפיה, דבר הופך את ביוסויל לחברה מובילה בביצוע פרויקטים סביבתיים מורכבים, ולשלם הגדול מסך חלקיו.